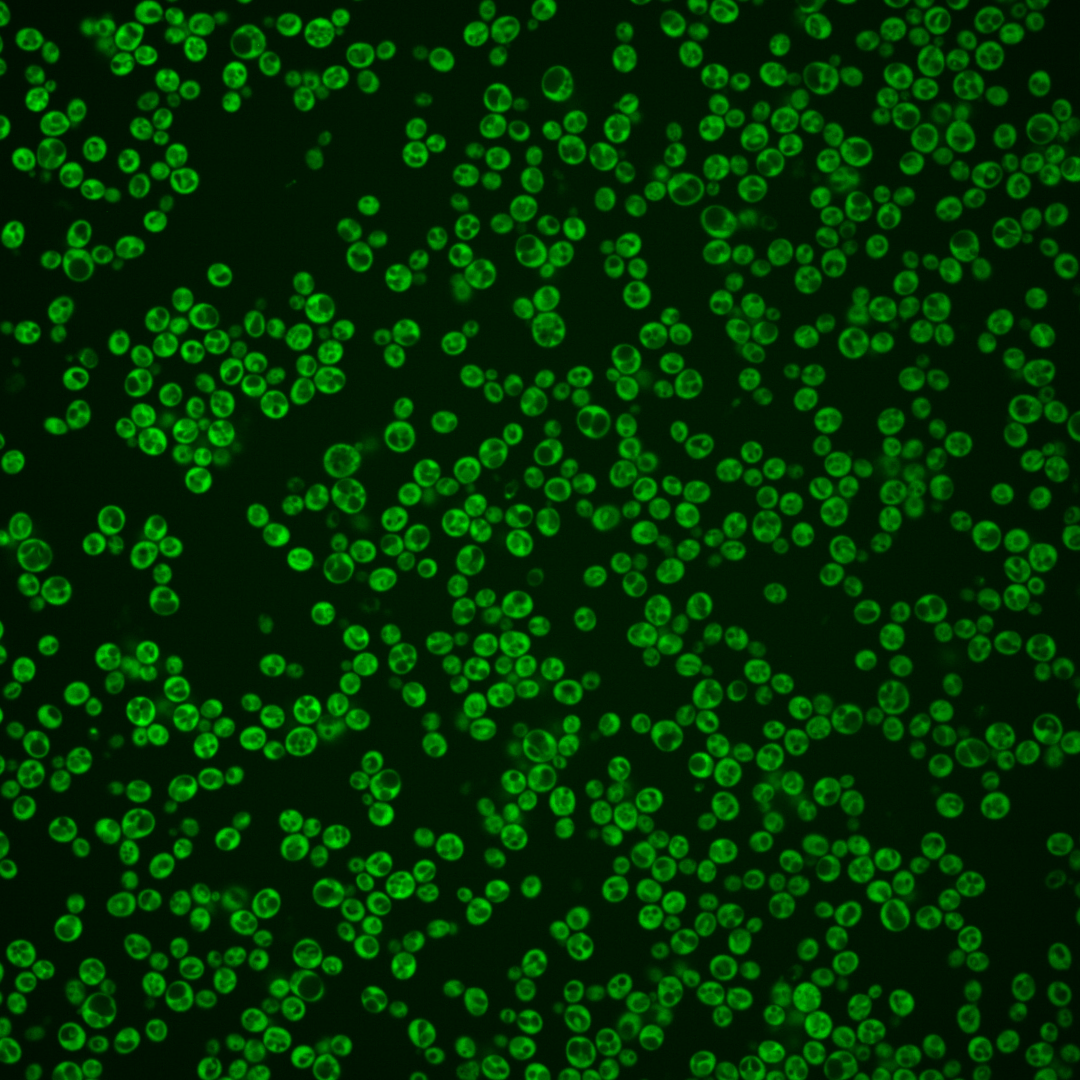
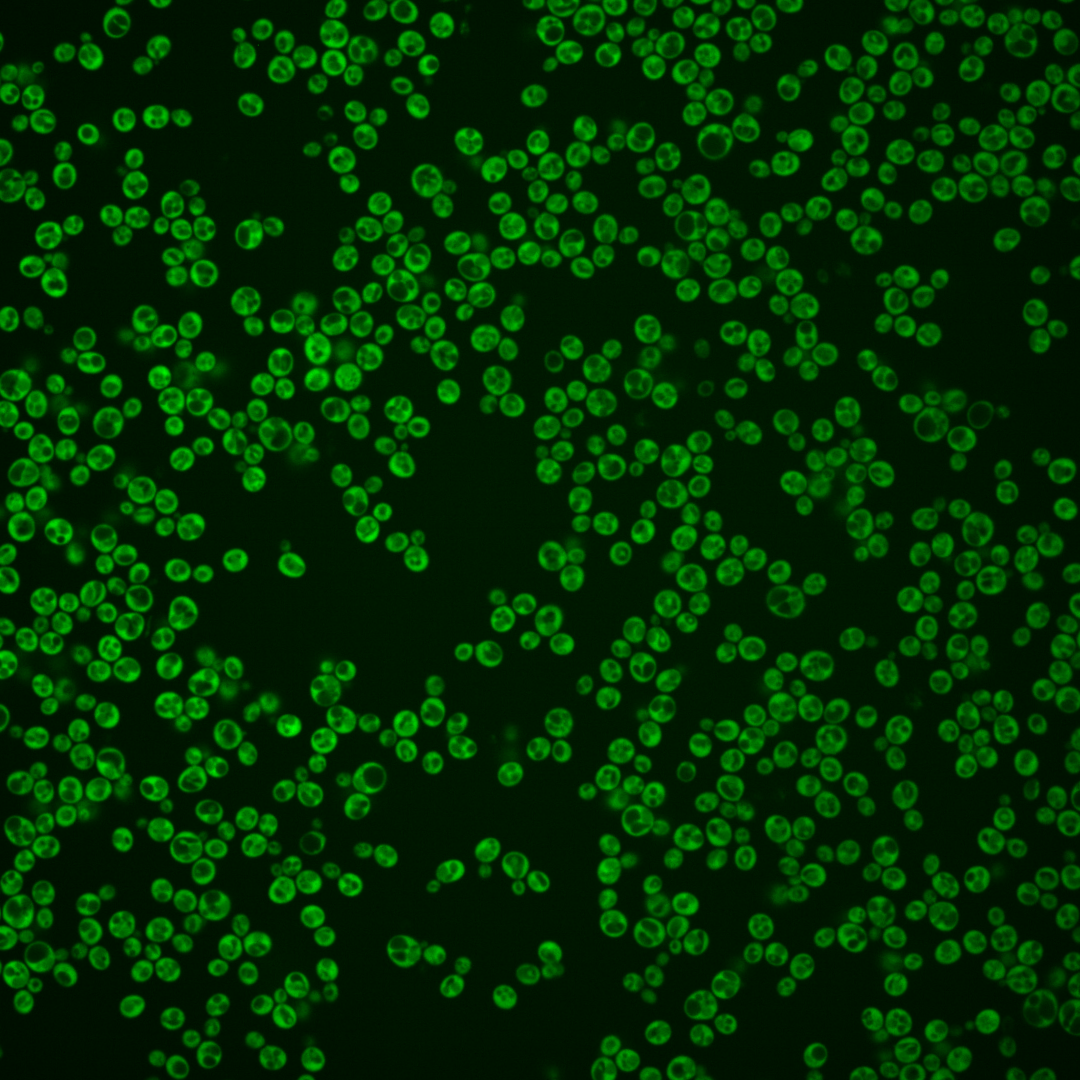
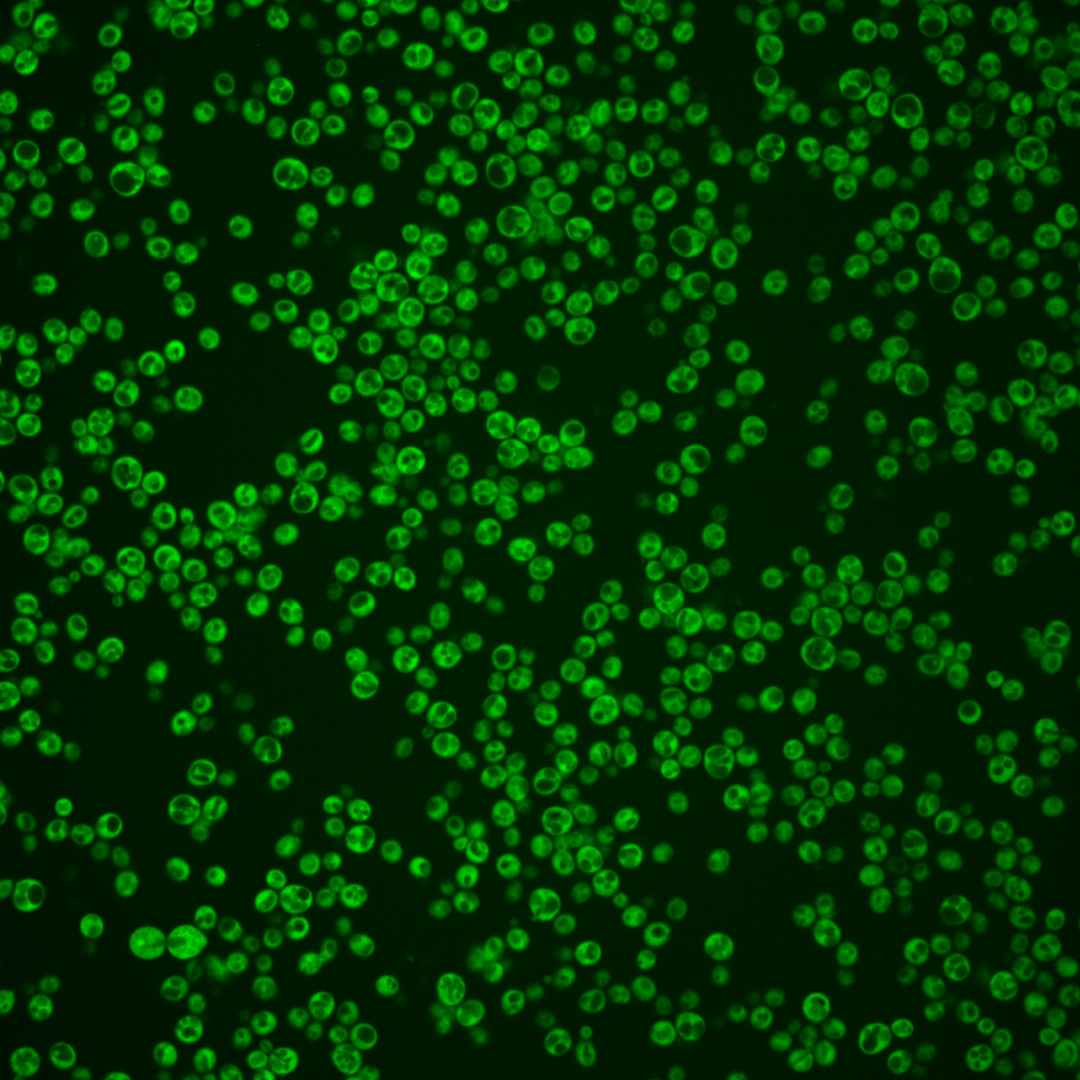
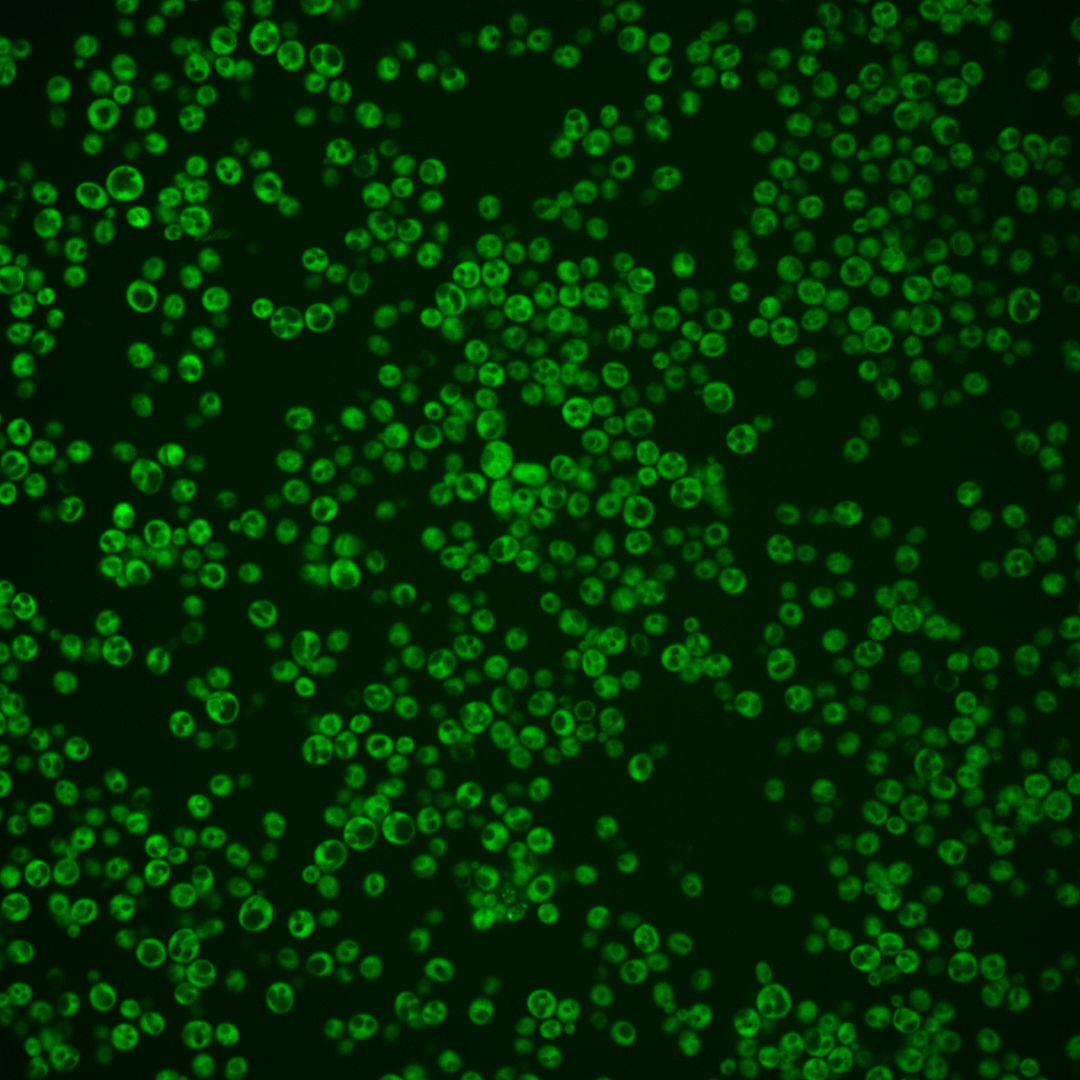
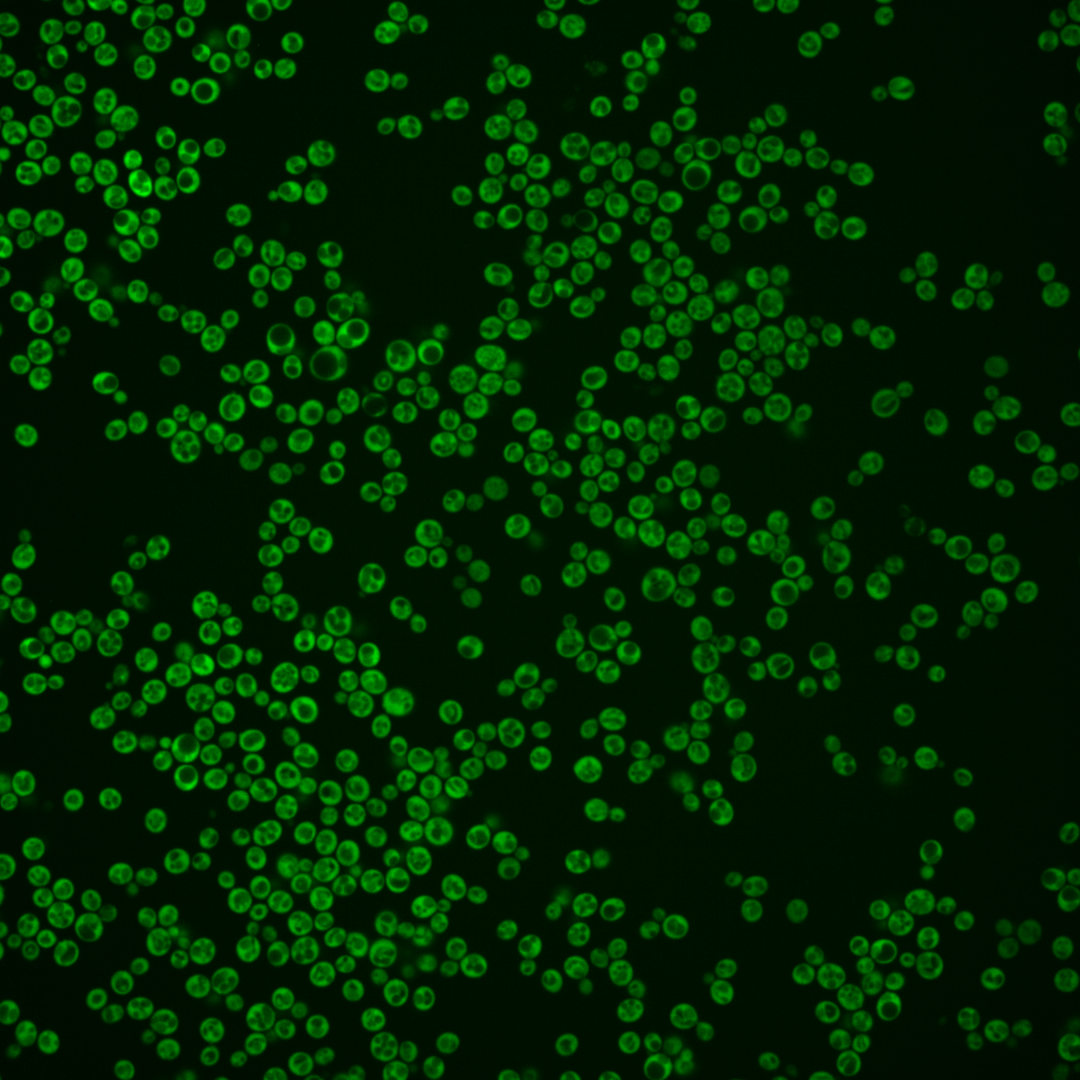
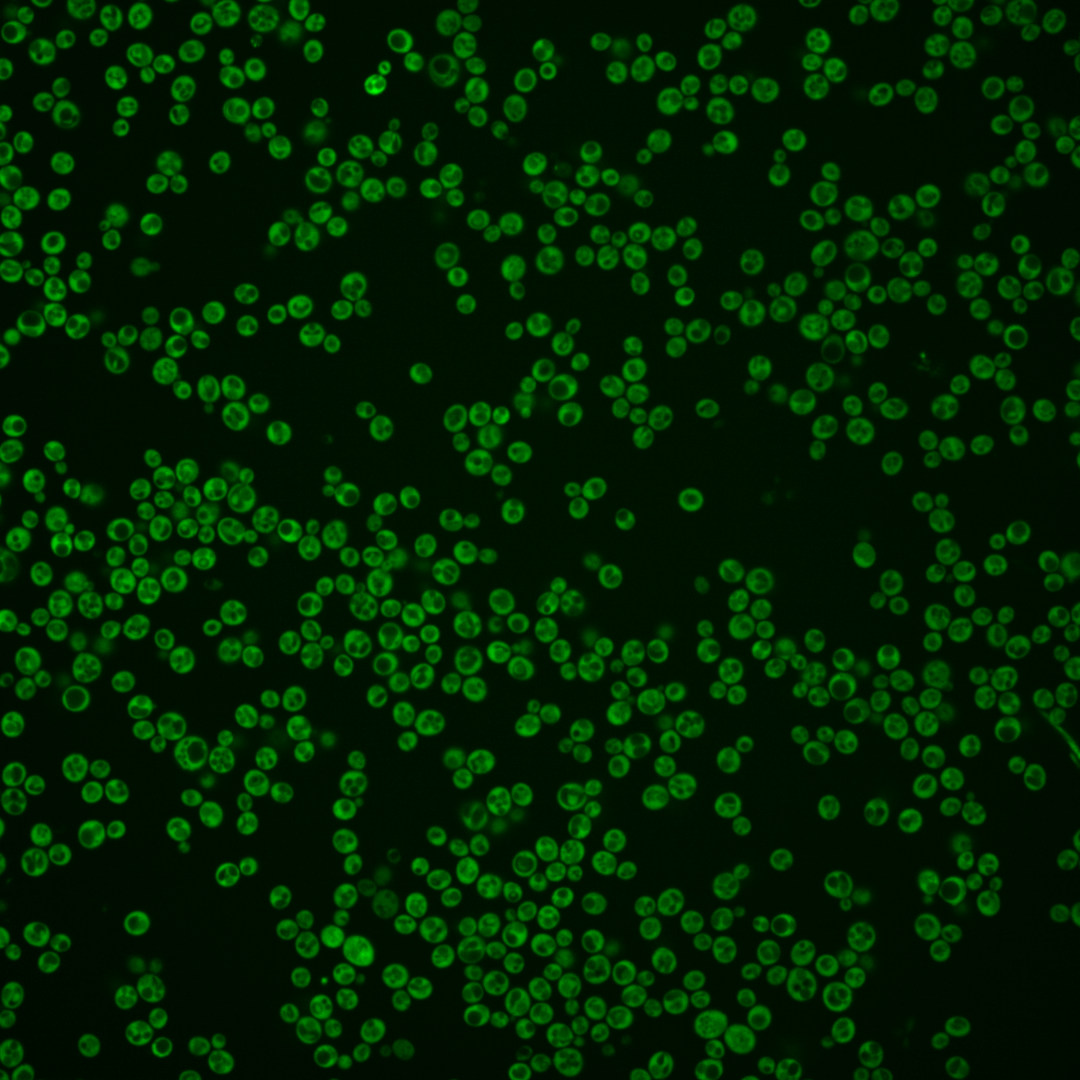
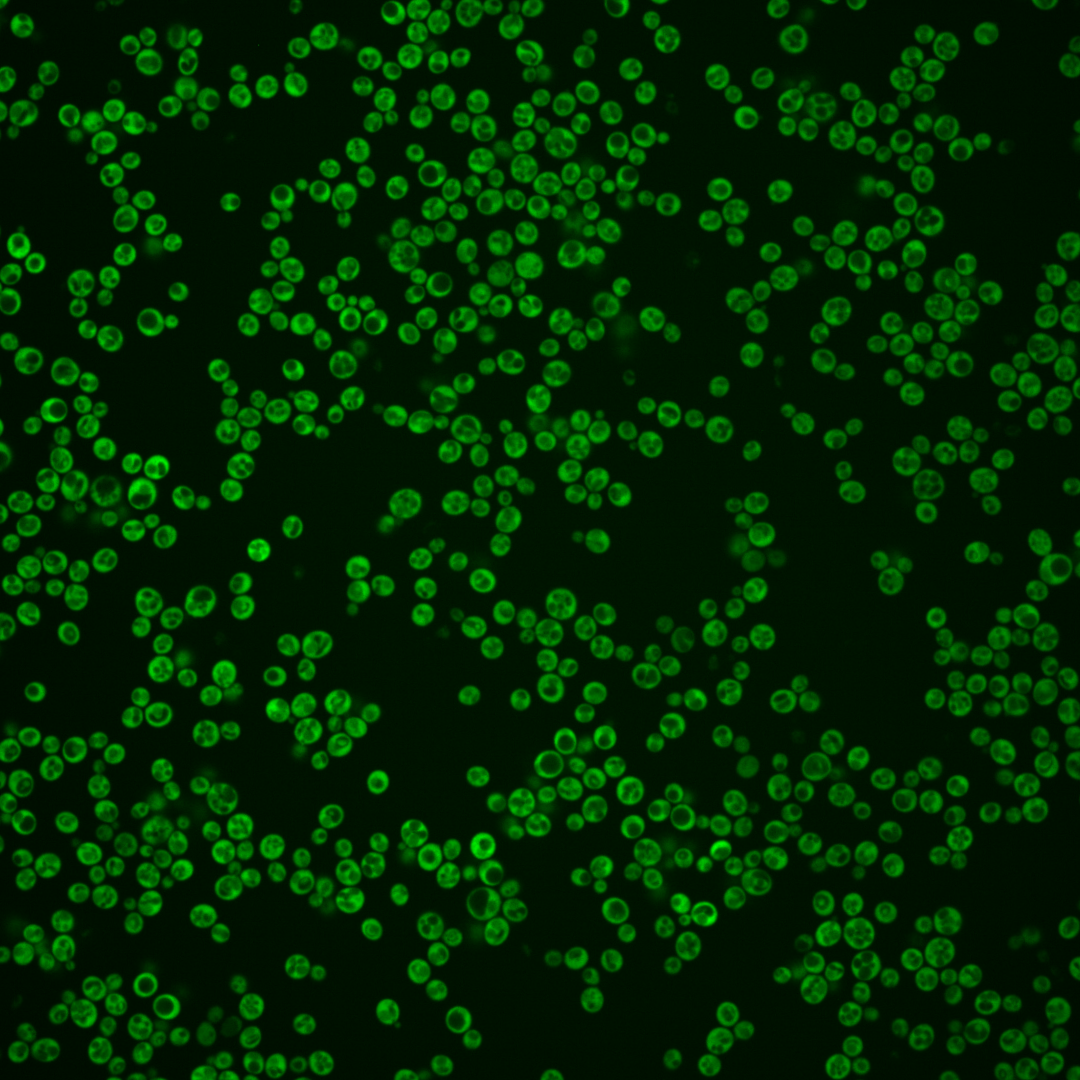
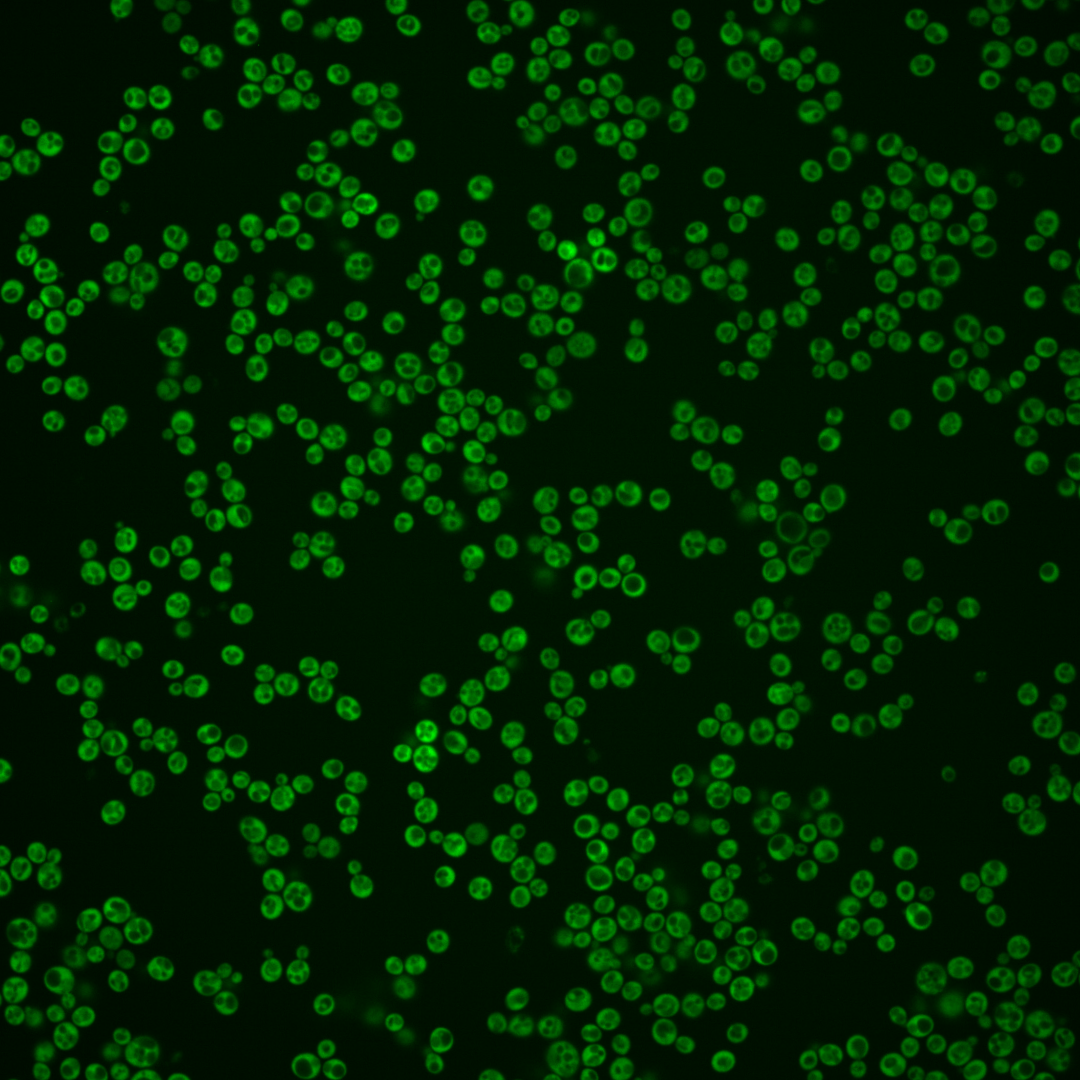

| Standard name | |
|---|---|
| Human Ortholog | |
| Description | Protein component of the small (40S) ribosomal subunit; homologous to mammalian ribosomal protein S6, no bacterial homolog; phosphorylated on S233 by Ypk3p in a TORC1-dependent manner, and on S232 in a TORC1/2-dependent manner by Ypk1/2/3p; RPS6B has a paralog, RPS6A, that arose from the whole genome duplication |
Micrographs




















































































Sub-cellular Localization
Yeast GFP Assignment
Protein Abundance
Localization Change
External localization resources
| ensLOC | DeepLoc | |||||||||||||||||||||||
|---|---|---|---|---|---|---|---|---|---|---|---|---|---|---|---|---|---|---|---|---|---|---|---|---|
| Localization | WT1 | WT2 | WT3 | RAP60 | RAP140 | RAP220 | RAP300 | RAP380 | RAP460 | RAP540 | RAP620 | RAP700 | HU80 | HU120 | HU160 | rpd3Δ_1 | rpd3Δ_2 | rpd3Δ_3 | WT1 | WT2 | WT3 | AF100 | AF140 | AF180 |
| Cortical Patches | 0 | 0 | 0 | 1 | 2 | 1 | 9 | 9 | 9 | 6 | 5 | 0 | – | 1 | 0 | 1 | 1 | 1 | 0 | 0 | 0 | 0 | 0 | 0 |
| Bud | 0 | 0 | 0 | 0 | 0 | 0 | 2 | 0 | 0 | 0 | 0 | 0 | – | 0 | 0 | 0 | 0 | 0 | 0 | 0 | 0 | 0 | 1 | 0 |
| Bud Neck | 0 | 0 | 0 | 0 | 0 | 0 | 0 | 0 | 0 | 0 | 0 | 0 | – | 0 | 0 | 0 | 0 | 0 | 0 | 0 | 0 | 0 | 0 | 0 |
| Bud Site | 0 | 0 | 0 | 0 | 0 | 0 | 0 | 0 | 0 | 0 | 0 | 0 | – | 0 | 0 | 0 | 0 | 0 | – | – | – | – | – | – |
| Cell Periphery | 0 | 1 | 4 | 4 | 4 | 6 | 12 | 10 | 6 | 9 | 5 | 0 | – | 4 | 2 | 18 | 2 | 8 | 0 | 0 | 0 | 0 | 0 | 1 |
| Cytoplasm | 146 | 133 | 108 | 124 | 129 | 102 | 163 | 128 | 88 | 105 | 58 | 40 | – | 118 | 114 | 250 | 199 | 264 | 142 | 151 | 116 | 96 | 94 | 149 |
| Endoplasmic Reticulum | 3 | 1 | 6 | 7 | 10 | 6 | 23 | 40 | 15 | 20 | 9 | 5 | – | 1 | 4 | 8 | 8 | 10 | 3 | 2 | 5 | 11 | 14 | 11 |
| Endosome | 0 | 0 | 0 | 0 | 0 | 0 | 0 | 0 | 0 | 0 | 0 | 0 | – | 0 | 0 | 0 | 0 | 0 | 0 | 0 | 0 | 0 | 0 | 1 |
| Golgi | 0 | 0 | 0 | 1 | 3 | 2 | 4 | 2 | 3 | 3 | 0 | 2 | – | 0 | 0 | 2 | 4 | 0 | 0 | 0 | 0 | 0 | 0 | 0 |
| Mitochondria | 0 | 1 | 0 | 6 | 0 | 17 | 37 | 30 | 60 | 52 | 53 | 27 | – | 0 | 0 | 0 | 4 | 8 | 2 | 0 | 1 | 0 | 5 | 3 |
| Nucleus | 0 | 0 | 0 | 1 | 1 | 2 | 2 | 2 | 0 | 1 | 0 | 2 | – | 0 | 2 | 1 | 1 | 0 | 1 | 0 | 0 | 0 | 0 | 0 |
| Nuclear Periphery | 0 | 0 | 0 | 0 | 0 | 0 | 1 | 1 | 1 | 0 | 4 | 0 | – | 0 | 0 | 0 | 0 | 0 | 0 | 0 | 0 | 0 | 0 | 0 |
| Nucleolus | 0 | 0 | 0 | 0 | 0 | 0 | 0 | 0 | 0 | 1 | 1 | 1 | – | 0 | 0 | 0 | 0 | 0 | 0 | 0 | 0 | 0 | 0 | 0 |
| Peroxisomes | 0 | 0 | 0 | 0 | 0 | 0 | 0 | 0 | 0 | 0 | 0 | 0 | – | 0 | 0 | 0 | 0 | 0 | 0 | 0 | 0 | 0 | 0 | 1 |
| SpindlePole | 0 | 0 | 0 | 0 | 0 | 0 | 0 | 0 | 0 | 0 | 0 | 0 | – | 0 | 0 | 0 | 0 | 0 | 0 | 0 | 0 | 0 | 0 | 0 |
| Vac/Vac Membrane | 0 | 1 | 0 | 5 | 7 | 4 | 10 | 6 | 5 | 12 | 5 | 5 | – | 1 | 0 | 12 | 13 | 4 | 0 | 3 | 2 | 1 | 2 | 2 |
| Unique Cell Count | 149 | 136 | 114 | 137 | 149 | 123 | 223 | 199 | 154 | 179 | 119 | 75 | 122 | 116 | 270 | 213 | 274 | 153 | 158 | 128 | 114 | 121 | 173 | |
| Labelled Cell Count | 149 | 137 | 118 | 149 | 156 | 140 | 263 | 228 | 187 | 209 | 140 | 82 | 125 | 122 | 292 | 232 | 295 | 153 | 158 | 128 | 114 | 121 | 173 | |
Yeast GFP Assignment
Protein Abundance
| Screen | WT1 | WT2 | WT3 | RAP60 | RAP140 | RAP220 | RAP300 | RAP380 | RAP460 | RAP540 | RAP620 | RAP700 | HU80 | HU120 | HU160 | rpd3Δ_1 | rpd3Δ_2 | rpd3Δ_3 | AF100 | AF140 | AF180 |
|---|---|---|---|---|---|---|---|---|---|---|---|---|---|---|---|---|---|---|---|---|---|
| Mean Cell GFP Intensity (1e-4) | 15.8 | 22.8 | 15.4 | 17.0 | 16.6 | 13.4 | 12.9 | 12.7 | 11.8 | 11.9 | 11.1 | 10.8 | – | 18.9 | 18.2 | 24.3 | 24.5 | 25.4 | 18.0 | 15.6 | 18.0 |
| Std Deviation (1e-4) | 2.9 | 4.0 | 2.5 | 2.9 | 3.0 | 3.1 | 3.1 | 2.8 | 2.5 | 2.8 | 2.7 | 2.4 | – | 3.2 | 3.6 | 6.1 | 6.1 | 6.4 | 4.2 | 4.0 | 4.4 |
| Intensity Change (Log2) | – | – | – | 0.14 | 0.11 | -0.2 | -0.25 | -0.28 | -0.38 | -0.37 | -0.47 | -0.5 | – | 0.3 | 0.25 | 0.66 | 0.67 | 0.73 | 0.23 | 0.02 | 0.23 |
Localization Change
| Localization | RAP60 | RAP140 | RAP220 | RAP300 | RAP380 | RAP460 | RAP540 | RAP620 | RAP700 | HU80 | HU120 | HU160 | rpd3Δ_1 | rpd3Δ_2 | rpd3Δ_3 |
|---|---|---|---|---|---|---|---|---|---|---|---|---|---|---|---|
| Cortical Patches | 0 | 0 | 0 | 0 | 0 | 0 | 0 | 0 | 0 | – | 0 | 0 | 0 | 0 | 0 |
| Bud | 0 | 0 | 0 | 0 | 0 | 0 | 0 | 0 | 0 | – | 0 | 0 | 0 | 0 | 0 |
| Bud Neck | 0 | 0 | 0 | 0 | 0 | 0 | 0 | 0 | 0 | – | 0 | 0 | 0 | 0 | 0 |
| Bud Site | 0 | 0 | 0 | 0 | 0 | 0 | 0 | 0 | 0 | – | 0 | 0 | 0 | 0 | 0 |
| Cell Periphery | 0 | 0 | 0 | 0.8 | 0.6 | 0 | 0.6 | 0 | 0 | – | 0 | 0 | 1.2 | 0 | 0 |
| Cytoplasm | -1.3 | -2.2 | -2.9 | -4.7 | -6.0 | -6.9 | -6.8 | -7.8 | -6.8 | – | 0.8 | 1.5 | -0.8 | -0.5 | 0.7 |
| Endoplasmic Reticulum | -0.1 | 0.5 | -0.1 | 1.6 | 3.6 | 1.3 | 1.7 | 0.7 | 0 | – | 0 | 0 | 0 | 0 | 0 |
| Endosome | 0 | 0 | 0 | 0 | 0 | 0 | 0 | 0 | 0 | – | 0 | 0 | 0 | 0 | 0 |
| Golgi | 0 | 0 | 0 | 0 | 0 | 0 | 0 | 0 | 0 | – | 0 | 0 | 0 | 0 | 0 |
| Mitochondria | 0 | 0 | 4.1 | 4.6 | 4.4 | 7.6 | 6.3 | 8.1 | 6.9 | – | 0 | 0 | 0 | 0 | 0 |
| Nucleus | 0 | 0 | 0 | 0 | 0 | 0 | 0 | 0 | 0 | – | 0 | 0 | 0 | 0 | 0 |
| Nuclear Periphery | 0 | 0 | 0 | 0 | 0 | 0 | 0 | 0 | 0 | – | 0 | 0 | 0 | 0 | 0 |
| Nucleolus | 0 | 0 | 0 | 0 | 0 | 0 | 0 | 0 | 0 | – | 0 | 0 | 0 | 0 | 0 |
| Peroxisomes | 0 | 0 | 0 | 0 | 0 | 0 | 0 | 0 | 0 | – | 0 | 0 | 0 | 0 | 0 |
| SpindlePole | 0 | 0 | 0 | 0 | 0 | 0 | 0 | 0 | 0 | – | 0 | 0 | 0 | 0 | 0 |
| Vacuole | 0 | 0 | 0 | 0 | 0 | 0 | 0 | 0 | 0 | – | 0 | 0 | 0 | 0 | 0 |
External localization resources
Images






























Protein Concentration and Protein Localization Data
| R1 | R2 | R3 | ||||||||||||||||
|---|---|---|---|---|---|---|---|---|---|---|---|---|---|---|---|---|---|---|
| G1 Pre-START | G1 Post-START | S/G2 | Metaphase | Anaphase | Telophase | G1 Pre-START | G1 Post-START | S/G2 | Metaphase | Anaphase | Telophase | G1 Pre-START | G1 Post-START | S/G2 | Metaphase | Anaphase | Telophase | |
| Concentration | 26.5211 | 34.9736 | 32.25 | 31.2431 | 25.0575 | 32.0047 | 27.232 | 33.8451 | 31.8206 | 27.9101 | 29.4427 | 30.8481 | 28.2795 | 37.4315 | 32.7429 | 23.9491 | 28.6654 | 32.9587 |
| Actin | 0.0046 | 0.0015 | 0.0004 | 0.001 | 0.0044 | 0.0008 | 0.004 | 0.0011 | 0.0005 | 0.0003 | 0.0005 | 0.0016 | 0.0013 | 0.0038 | 0.0019 | 0.005 | 0.0022 | 0.0022 |
| Bud | 0.0012 | 0.0005 | 0.0006 | 0.0051 | 0.0031 | 0.0008 | 0.0008 | 0.0004 | 0.0006 | 0.0009 | 0.0009 | 0.0012 | 0.005 | 0.006 | 0.0068 | 0.0203 | 0.009 | 0.0044 |
| Bud Neck | 0.0011 | 0.0004 | 0.0006 | 0.0008 | 0.0009 | 0.0013 | 0.0006 | 0.0004 | 0.0007 | 0.0012 | 0.0011 | 0.0015 | 0.0014 | 0.0012 | 0.0016 | 0.0026 | 0.0028 | 0.0048 |
| Bud Periphery | 0.0022 | 0.0008 | 0.0004 | 0.0227 | 0.0061 | 0.0008 | 0.0011 | 0.0002 | 0.0007 | 0.0004 | 0.0008 | 0.0018 | 0.0087 | 0.0042 | 0.0092 | 0.0224 | 0.0155 | 0.0097 |
| Bud Site | 0.001 | 0.0006 | 0.0004 | 0.0007 | 0.002 | 0.0001 | 0.0005 | 0.0004 | 0.0003 | 0.0002 | 0.0001 | 0.0001 | 0.0024 | 0.0074 | 0.005 | 0.0036 | 0.0016 | 0.0005 |
| Cell Periphery | 0.0041 | 0.0031 | 0.0014 | 0.0018 | 0.0053 | 0.0009 | 0.0047 | 0.0006 | 0.0012 | 0.0009 | 0.0005 | 0.0022 | 0.0073 | 0.0035 | 0.0103 | 0.0048 | 0.0031 | 0.0054 |
| Cytoplasm | 0.7342 | 0.9292 | 0.8731 | 0.8014 | 0.7014 | 0.8285 | 0.7535 | 0.9226 | 0.8729 | 0.8707 | 0.8226 | 0.7932 | 0.6743 | 0.8527 | 0.727 | 0.5542 | 0.7133 | 0.6935 |
| Cytoplasmic Foci | 0.0073 | 0.0034 | 0.0095 | 0.0054 | 0.0257 | 0.0095 | 0.0057 | 0.0052 | 0.0066 | 0.0097 | 0.0136 | 0.0108 | 0.004 | 0.0031 | 0.0042 | 0.0046 | 0.0089 | 0.0068 |
| Eisosomes | 0.0001 | 0.0001 | 0 | 0 | 0.0005 | 0 | 0.0001 | 0 | 0 | 0 | 0 | 0 | 0 | 0.0001 | 0 | 0 | 0 | 0.0001 |
| Endoplasmic Reticulum | 0.0823 | 0.0244 | 0.0223 | 0.0084 | 0.0277 | 0.0707 | 0.1063 | 0.0319 | 0.0378 | 0.0175 | 0.0474 | 0.0875 | 0.1042 | 0.0397 | 0.045 | 0.0394 | 0.036 | 0.1188 |
| Endosome | 0.0367 | 0.0075 | 0.0244 | 0.0232 | 0.0536 | 0.0411 | 0.0322 | 0.0132 | 0.0221 | 0.0392 | 0.067 | 0.0439 | 0.0132 | 0.0072 | 0.0086 | 0.017 | 0.0346 | 0.0294 |
| Golgi | 0.0057 | 0.0022 | 0.0023 | 0.0028 | 0.0049 | 0.0069 | 0.0055 | 0.0046 | 0.0024 | 0.0038 | 0.0092 | 0.0132 | 0.0016 | 0.0021 | 0.0018 | 0.001 | 0.0035 | 0.0073 |
| Lipid Particles | 0.0013 | 0.0004 | 0.0014 | 0.0004 | 0.0118 | 0.0002 | 0.0006 | 0.0002 | 0.0003 | 0.0002 | 0.0001 | 0.0002 | 0.001 | 0.0004 | 0.0015 | 0.0009 | 0.0012 | 0.0004 |
| Mitochondria | 0.011 | 0.0045 | 0.0021 | 0.0126 | 0.0172 | 0.007 | 0.0051 | 0.0017 | 0.0016 | 0.0005 | 0.0059 | 0.0175 | 0.0032 | 0.001 | 0.0025 | 0.0019 | 0.0018 | 0.0113 |
| None | 0.0038 | 0.0015 | 0.003 | 0.0009 | 0.0158 | 0.0006 | 0.0008 | 0.0002 | 0.0003 | 0.0002 | 0.0003 | 0.0006 | 0.0012 | 0.0006 | 0.0016 | 0.0013 | 0.0014 | 0.0007 |
| Nuclear Periphery | 0.0162 | 0.0017 | 0.0042 | 0.0036 | 0.0166 | 0.0035 | 0.0113 | 0.0014 | 0.003 | 0.003 | 0.0021 | 0.0038 | 0.016 | 0.0054 | 0.0111 | 0.0261 | 0.0179 | 0.0095 |
| Nucleolus | 0.0013 | 0.0001 | 0.0018 | 0.0003 | 0.0022 | 0 | 0.0001 | 0.0001 | 0 | 0 | 0 | 0 | 0.001 | 0.0007 | 0.0011 | 0.0037 | 0.0021 | 0.001 |
| Nucleus | 0.007 | 0.0012 | 0.0044 | 0.0025 | 0.0082 | 0.0015 | 0.003 | 0.0018 | 0.0013 | 0.0018 | 0.0012 | 0.0012 | 0.0765 | 0.0322 | 0.0855 | 0.1284 | 0.0647 | 0.046 |
| Peroxisomes | 0.0007 | 0.0001 | 0.0002 | 0.0003 | 0.0007 | 0.0001 | 0.0006 | 0 | 0 | 0.0001 | 0.0001 | 0.0001 | 0.0007 | 0.0001 | 0.0001 | 0.0001 | 0.0001 | 0.0001 |
| Punctate Nuclear | 0.0022 | 0.0001 | 0.001 | 0.0001 | 0.0067 | 0.0004 | 0.0001 | 0 | 0.0001 | 0 | 0 | 0.0001 | 0.0058 | 0.0018 | 0.0101 | 0.0078 | 0.0083 | 0.0062 |
| Vacuole | 0.063 | 0.0147 | 0.0377 | 0.0911 | 0.0627 | 0.0186 | 0.054 | 0.0129 | 0.042 | 0.0436 | 0.0202 | 0.015 | 0.0615 | 0.0247 | 0.0591 | 0.141 | 0.0627 | 0.0335 |
| Vacuole Periphery | 0.0132 | 0.0021 | 0.0087 | 0.015 | 0.0225 | 0.0067 | 0.0095 | 0.0012 | 0.0057 | 0.0057 | 0.0065 | 0.0044 | 0.0094 | 0.0021 | 0.0059 | 0.0136 | 0.0093 | 0.0083 |
Sequencing Data
| R1 | R2 | |||||||||
|---|---|---|---|---|---|---|---|---|---|---|
| G1 Post-START | S/G2 | Metaphase | Anaphase | Telophase | G1 Post-START | S/G2 | Metaphase | Anaphase | Telophase | |
| Gene Expression | 3217.099 | 3609.7761 | 4404.9848 | 3396.6013 | 4039.3161 | 3894.6761 | 3130.8397 | 2957.1173 | 3409.6389 | 2838.0761 |
| Translational Efficiency | 0.9071 | 0.9111 | 0.789 | 1.0834 | 0.9361 | 0.7032 | 0.8985 | 1.0558 | 0.8812 | 0.9719 |
Hit Data
| Dataset | Hit |
|---|---|
| Protein Concentration | ✔ |
| Protein Localization | ✘ |
| Gene Expression | ✘ |
| Translational Efficiency | ✘ |
Endocytosis
| Temp | Actin Patch (Sac6-tdTomato) | Cortical Patch (Sla1-GFP) | Late Endosome (Snf7-GFP) | Vacuole (Vph1-GFP) |
|---|---|---|---|---|
| 37℃ | ||||
| RT |
Cell Cycle Omics
CYCLoPs (Rps6b-GFP)
| Gene / Allele | Actin Patch (Sac6-tdTomato) | Cortical Patch (Sla1-GFP) | Late Endosome (Snf7-GFP) | Vacuole (Sac6-tdTomato) |
|---|
| Gene | Images |
|---|
| Gene | Images |
|---|
Images are not yet available
Images are not yet available